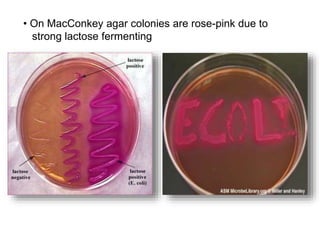
• On MacConkey agar colonies are rose-pink due to
strong lactose fermenting

The document describes several members of the Enterobacteriaceae family of bacteria, including Escherichia coli, Klebsiella, and Proteus. It discusses their morphological, cultural, and biochemical characteristics. Members of Enterobacteriaceae are typically gram-negative, facultative anaerobic rods that can be cultured on MacConkey agar. The document outlines the biochemical reactions and properties used to differentiate between lactose-fermenting and non-lactose fermenting bacteria such as E. coli, Klebsiella, and Proteus.